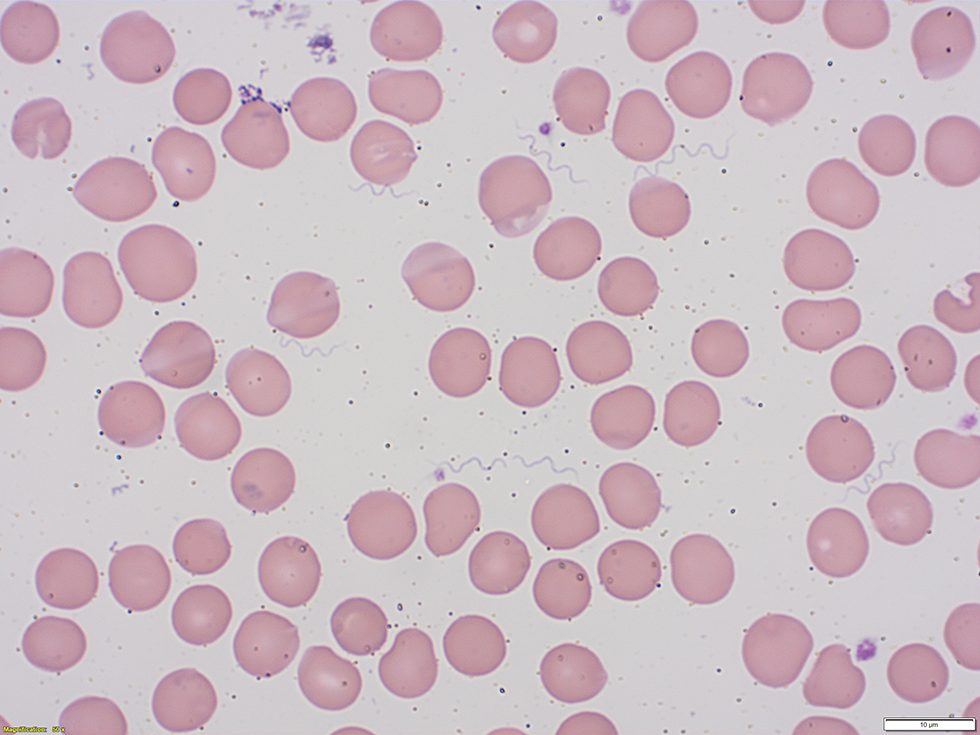
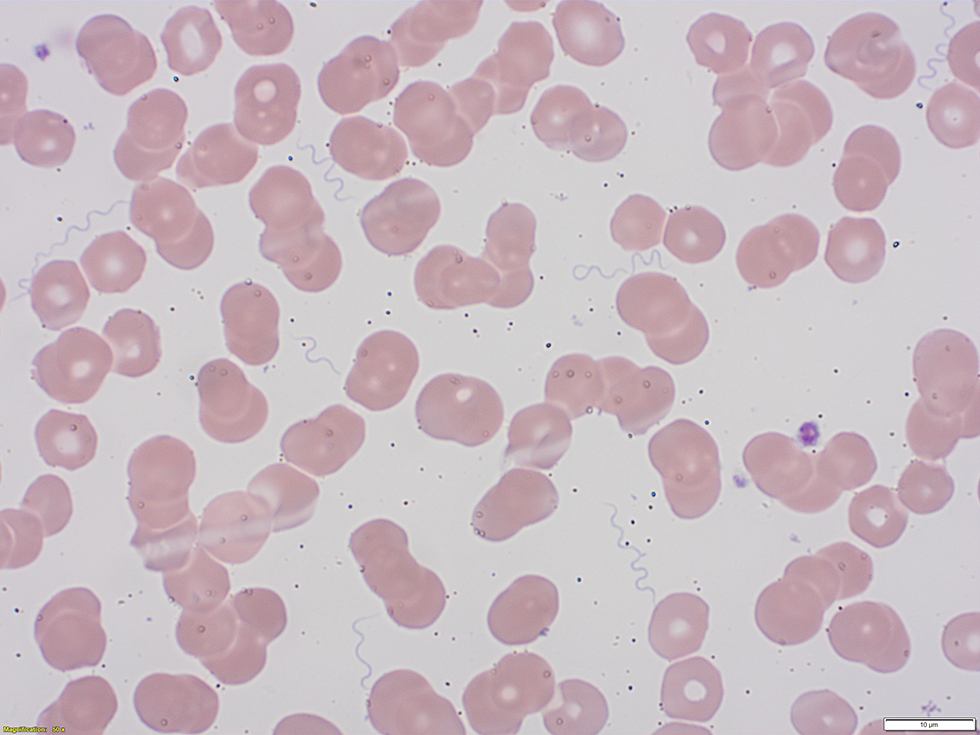

La fièvre à tiques pendant la grossesse

Téléchargez cet article en format PDFPublié par : L’Agence de la santé publique du Canada
Numéro : Volume 46–10 : Biosécurité en Laboratoire
Date de publication : 1er octobre 2020
ISSN : 1719-3109
Soumettre un article
À propos du RMTC
Naviguer
Volume 46–10, le 1er octobre 2020 : Biosécurité en Laboratoire
Étude de cas
Un cas de fièvre récurrente à tiques pendant la grossesse
John C Lam1, Oscar E Larios1,2, Michael D Parkins1,3, Stephen D Vaughan1
Affiliations
1 Division des maladies infectieuses, Département de médecine, Université de Calgary, Calgary, AB
2 Département de pathologie et de médecine de laboratoire, Université de Calgary, Calgary, AB
3 Département de microbiologie, d’immunologie et de maladies infectieuses, Université de Calgary, Calgary, AB
Correspondance
Citation proposée
Lam JC, Larios OE, Parkins MD, Vaughan SD. Un cas de fièvre récurrente transmise par les tiques pendant la grossesse Relevé des maladies transmissibles au Canada 2020;46(10):408–10. https://doi.org/10.14745/ccdr.v46i10a09f
Mots-clés : fièvre récurrente à tiques, Borrelia hermsii, Ornithodoros, réaction de Jarisch-Herxheimer, surveillance de la maladie
Résumé
La fièvre récurrente à tiques, ou borréliose, est une infection causée par les spirochètes Borrelia. En Amérique du Nord, Borrelia hermsii est la cause la plus fréquente de la fièvre récurrente à tiques. Cette maladie à transmission vectorielle est transmise par Ornithodoros hermsi, une tique à corps mou que l’on trouve en haute altitude dans le nord-ouest des États-Unis et le sud-ouest du Canada. Une fois la personne piquée par la tique et infectée par B. hermsii, elle peut avoir des épisodes de fièvre alternant avec des périodes a fébriles.
Un cas de fièvre récurrente à tiques chez une hôte enceinte a été compliqué par la réaction de Jarisch-Herxheimer et a exigé des soins intensifs. Ce cas démontre l’importance de garder un indice de suspicion élevé en matière de fièvre récurrente à tiques. Il convient donc de renforcer la reconnaissance, la capacité de diagnostic et le traitement de la fièvre récurrente à tiques par les cliniciens, ainsi que de sensibiliser le public aux stratégies de prévention des piqûres de tiques.
Introduction
La fièvre récurrente à tiques, ou borréliose, peut être difficile à diagnostiquer en raison de la difficulté à isoler la bactérie responsable, Borrelia hermsii, en laboratoire. De plus, puisque le vecteur est rarement reconnu, les cliniciens pourraient ne pas tenir compte de ce type de fièvre dans le diagnostic différentiel des maladies fébriles. Il ne faut pas oublier non plus que la fièvre récurrente à tiques n’est pas une maladie à déclaration obligatoire.
Nous abordons ici un cas de fièvre récurrente à tiques potentiellement mortel chez une personne enceinte, discutons de certains aspects du traitement et préconisons une surveillance active des cas par les responsables de la santé publique dans les zones à haut risque.
Le consentement éclairé écrit de la patiente a été obtenu pour la publication de ce rapport de cas et des images qui l’accompagnent.
Cas
Une femme primigeste de 30 ans, auparavant en bonne santé, qui en était à 17 semaines de gestation, s’est présentée à l’hôpital de Calgary, en Alberta, avec un historique de quatre jours de fièvres, de frissons et de multiples épisodes de vomissements. Avant l’apparition des symptômes, elle avait passé cinq jours dans la région de l’Okanagan, en Colombie-Britannique, pour effectuer une randonnée estivale en famille. Toute la famille a séjourné dans une maison bien entretenue et climatisée à Vernon, en Colombie-Britannique, qu’habitent régulièrement les membres de sa famille élargie. Il n’y avait aucun antécédent de présence de rongeurs ou de lutte antiparasitaire dans la maison ou autour de celle-ci.
La patiente avait eu une évolution prénatale peu remarquable, avec sérologie de dépistage négative pour la syphilis et le VIH. Il n’y avait eu aucun antécédent d’exposition correspondant à la fièvre associée à une morsure de rat, à la leptospirose ou à la fièvre récurrente à poux. Elle a cependant indiqué de multiples piqûres d’insectes inconnus sur sa poitrine, sans éruption, pendant ses vacances. Lorsqu’elle s’est présentée à l’hôpital, elle était fébrile (température de 38,9 °C), hypotendue (pression sanguine de 85/52) et souffrait de tachycardie (rythme cardiaque de 128 battements/minute). Le reste de son examen était par ailleurs sans lien avec son état actuel.
Les premières investigations ont permis d’identifier une pancytopénie avec une valeur d’hémoglobine de 78 g/L, de plaquettes de 27 × 109/L, de globules blancs de 3,4 × 109/L et de lymphopénie de 0,1 × 109/L. Une acidose métabolique avec pH de 7,21 et un lactate de 4,3 mmol/L ont également été indiqués. Un frottis sanguin périphérique a révélé la présence de spirochètes, ce qui a permis d’établir un diagnostic présumé de fièvre récurrente à tiques (figure 1).
Figure 1 : Frottis sanguin périphérique coloré par Wright-Giemsa montrant des spirochètes

Description textuelle : Figure 1
Figure 1 : Frottis sanguin périphérique coloré par Wright-Giemsa montrant des spirochètes
Cette figure montre la coloration Wright-Giemsa d’un frottis sanguin périphérique prélevé sur la patiente. Il montre la présence de nombreuses bactéries spirochètes extracellulaires.
Le traitement avec pénicilline G, à raison de quatre millions d’unités par intraveineuse aux quatre heures, a alors été entrepris. Deux heures après le début de l’administration de la pénicilline, la patiente a développé des frissons et son hypotension artérielle s’est aggravée (tension artérielle de 70/50) malgré l’administration de six litres de solutés cristalloïdes de réanimation, un résultat caractéristique d’une réaction de Jarisch-Herxheimer. La patiente a ensuite été transférée à l’unité de soins intensifs pour être surveillée plus attentivement. Son hypotension a disparu en un jour alors que sa pancytopénie s’est améliorée en une semaine. Elle a reçu son congé et a dû recevoir un traitement de pénicilline G par voie intraveineuse pendant 14 jours. Les tests moléculaires de réaction en chaîne par polymérase ribosomale 16S ont confirmé que B. hermsii était l’agent pathogène responsable.
À 40 semaines, la patiente a ensuite accouché d’un enfant en bonne santé.
Discussion
B. hermsii est un spirochète qui joue un rôle dans la fièvre récurrente à tiques. B. hermsii est souvent présent dans les régions montagneuses d’Amérique du Nord, centrale et du Sud. Au Canada, environ 50 cas ont été déclarés au cours des deux dernières décenniesNote de bas de page 1. La fièvre récurrente à tiques est transmise par la tique molle Ornithodoros hermsiNote de bas de page 2 qui pique sa victime pendant la nuit. Les tiques O. hermsi sont présentes dans le sud de la Colombie-Britannique et le nord-ouest des États-Unis et préfèrent les forêts de conifères se trouvant entre 450 et 2 450 m d’altitude dans lesquelles on trouve des rongeurs tels les écureuils arboricoles et les tamiasNote de bas de page 3. Les tiques O. hermsi vivent dans le fond des nids des rongeurs et se nourrissent pendant la nuit. En l’absence de rongeurs, O. hermsi piquent des humains.
Les personnes infectées présentent des fièvres récurrentes caractéristiques qui durent trois jours, ponctuées par des périodes d’une semaine pendant lesquelles elles sont afébriles. Les épisodes de fièvre et de tachycardie, appelés « phases de frissons », sont suivis de « phases avec bouffées vasomotrices » avec hypotension transitoire des sueurs abondantes. L’acuité des symptômes de la patiente est probablement liée à l’immunosuppression relative associée à sa grossesse, comme l’ont indiqué des rapports faisant état d’une plus grande gravité des symptômes chez les patientes enceintesNote de bas de page 4. Le risque d’issues néonatales défavorables est bien documentéNote de bas de page 5.
La microscopie peut être utile pour diagnostiquer la fièvre récurrente à tiques puisque les spirochètes associés à B. hermsii sont faciles à voir, tout particulièrement lors des épisodes fébriles. La coloration de Wright-Giemsa des frottis de sang périphérique sont positifs pour la présence de spirochètes extracellulaires chez environ 70 % des patients, en particulier pendant la phase de bouffées vasomotricesNote de bas de page 6. Bien que les tests moléculaires puissent être utilisés pour confirmer les espèces de spirochètes, le délai d’exécution de ce test est long et il n’est pas approprié d’attendre les résultats avant d’entamer le traitement. De même, les tests sérologiques effectués quelques semaines après l’infection confirment la présence d’une réponse anticorps appropriée, mais sont peu utiles dans la gestion aiguë de la maladie.
La fièvre récurrente à tiques pendant la grossesse est rare, mais il est important de tenir compte de la pharmacothérapie et des répercussions sur le fœtus. La doxycycline orale ou les bêta-lactamines par voie intraveineuse sont des traitements appropriés, mais les bêta-lactamines sont préférables pendant la grossesse en raison de la tératogénicité des tétracyclinesNote de bas de page 7. La réaction de Jarisch-Herxheimer, caractérisée par des frissons, de la fièvre et une hypotension, peut se développer dans les 24 heures chez les patients traités pour des infections spirochétoses. La réaction de Jarisch-Herxheimer a été documentée chez plus de 50 % des patients traités pour une fièvre récurrente à tiquesNote de bas de page 8Note de bas de page 9. La thrombocytopénie associée à une fièvre récurrente à tiques aiguë entraîne des risques de travail prématuré et d’avortement spontané. Des cas de transmission placentaire au nouveau-né ont également été déclarésNote de bas de page 4.
Comme la fièvre récurrente à tiques n’est pas une maladie à déclaration obligatoire au Canada, on ignore si la répartition de B. hermsii et l’incidence de la fièvre récurrente à tiques sont similaires à celles d’il y a dix ans. Plus de 80 % des patients ne développeront aucune éruption cutanée à la suite d’une piqûre nocturne indolore ou ne présenteront pas de fièvre, même si ce syndrome est caractéristique de ce type de piqûre. Ainsi, le nombre de cas de fièvre récurrente à tiques dans le sud-ouest du Canada est probablement sous-estiméNote de bas de page 10. La surveillance et la déclaration des cas peuvent améliorer l’approche systémique du diagnostic et permettre de sensibiliser davantage les cliniciens à cette maladie.
Bien que rare, la fièvre récurrente à tiques peut avoir des séquelles graves et même être mortelleNote de bas de page 11. Une meilleure sensibilisation du public à la fièvre récurrente à tiques peut donner lieu à un effort plus concerté pour prévenir la maladie en réduisant le nombre d’habitats de rongeurs, en communiquant avec les services de lutte antiparasitaire pour que les zones infestées de rongeurs fassent l’objet d’un traitement chimique et en éduquant les gens à utiliser des répulsifs topiques (e.g. la perméthrine) avant de se coucherNote de bas de page 12. La surveillance active des cas pourrait être envisagée par les responsables de la santé publique dans les zones à haut risque.
La répartition géographique d’O. hermsi pourrait prendre de l’expansion au Canada en raison des changements climatiques prévusNote de bas de page 13.
Conclusion
Ce cas aborde la fièvre récurrente à tiques comme une complication potentiellement mortelle pendant la grossesse en l’absence d’exposition typique dans un cadre rustique.
Les données de surveillance seraient utiles pour caractériser l’épidémiologie de cette infection probablement sous-diagnostiquée au Canada.
Déclaration des auteurs
Tous les auteurs ont joué un rôle dans la prise en charge de la patiente. J. C. L. a rédigé l’ébauche initiale du manuscrit et tous les auteurs ont contribué à sa révision. S. D. V. a supervisé la préparation et les révisions du manuscrit. Tous les auteurs ont lu et approuvé le manuscrit final.
Une copie du consentement écrit est disponible pour examen par le rédacteur en chef du Relevé des maladies transmissibles au Canada.
Intérêts concurrentiels
Aucun.
Le cas a été présenté en partie aux Clinical Grand Rounds du European Congress of Clinical Microbiology & Infectious Diseases (ECCMID) qui s’est tenu à Amsterdam Noord aux Pays-Bas en 2019.
Financement
Cette recherche n’a reçu aucune subvention spécifique des organismes de financement des secteurs public, commercial ou à but non lucratif.

Cette œuvre est mise à disposition selon les termes de la Licence Creative Commons Attribution 4.0 International